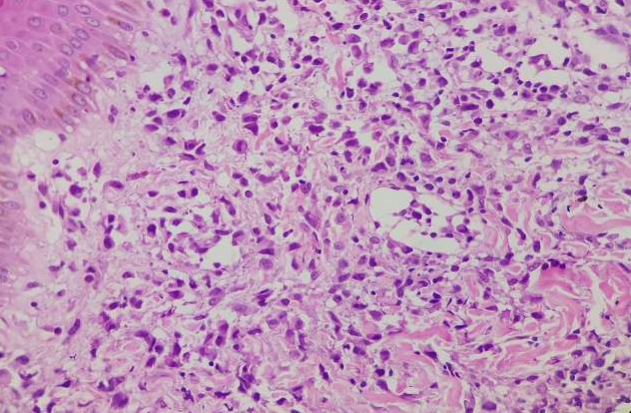

Lymphomatoid Papulosis Type C: Case Report and Review of Literature
Lymphomatoid Papulosis Type C: Case Report and Review of Literature
Dr Nidhun V Ashok *1, Dr. Karishma Abraham George 2
1.Medical Oncology, Department of Medical oncology, Basavatarakam Indo American Cancer Hospital and Research Centre, Hyderabad, Telangana, India.
2.Dept of Dermatology, Jubilee mission Medical College, Thrissur, Kerala.
*Correspondence to: Dr Nidhun V Ashok, Medical Oncology, Department of Medical oncology, Basavatarakam Indo American Cancer Hospital and Research Centre, Hyderabad, Telangana, India.
Copyright
© 2023 Dr Nidhun V Ashok. This is an open access article distributed under the Creative Commons Attribution License, which permits unrestricted use, distribution, and reproduction in any medium, provided the original work is properly cited.
Received: 15 November 2023
Published: 01 December 2023
Abstract
Lymphomatoid papulosis (LyP) is a rare CD30+ lymphoproliferative primary skin disease with a benign clinical manifestations and malignant histopathology. Based on histopathology, LyP is classified into five main subtypes: A through E. The present case report describes a 40-year-old female who had waxing and waning papular skin lesions in her left buttock for more than a year. She visited multiple dermatology physicians for one year without getting a definitive diagnosis. She underwent a skin biopsy and immunohistochemistry study (IHC)and was diagnosed with LyP subtype C. The patient was given topical corticosteroids and was put on a “wait and watch” strategy. She was counselled in detail regarding her disease status and the importance of clinical follow up in such conditions. After 6 months of follow-up, the disease remains indolent. Our case emphasizes the importance of considering such rare disease entities in differential diagnosis. It also emphasises the importance of proper patient counselling and education in such rare diseases where data is sparse.
Keywords: Anaplastic large cell lymphoma, Lymphomatoid papulosis, lymphoproliferative disorders, CD30+
Lymphomatoid Papulosis Type C: Case Report and Review of Literature
Introduction
Among the cutaneous CD30+ lymphoproliferative disorders (LPDs), lymphomatoid papulosis (LyP) is a rare, recurrent, self-healing papulonodular skin eruption. There is a lifelong increase in the incidence of malignant lymphoma.[1] LyP belongs to a spectrum of CD30-positive cutaneous lymphoproliferative diseases (CD30+LPDs), including primary cutaneous anaplastic large cell lymphoma (ALCL), lymphomatoid papulosis, and borderline CD30+lesions according to the WHO classification.[2] Clinically, the eruption exhibits a red-brown papulonodular appearance that may become necrotic and hemorrhagic. Within two to twelve weeks, the lesions regress, leaving hypopigmented, hyperpigmented, or distinctive atrophic scars.[3] The etiology of lymphomatoid papulosis is unknown. A viral etiology has been suggested. There may be an interaction between CD30 and its ligand (CD30L) that triggers apoptosis of neoplastic T cells and the regression of the lesions, but the exact mechanism is still a unknown.[4] This case report describes a 40-year-old female with multiple popular skin lesions in the left buttock area which was waxing and waning in nature for a duration of more than a year. She was visiting multiple dermatology physicians over time for getting diagnosed. In our case, we emphasize the importance of considering such rare disease entities in differential diagnoses and further treatment options.
Case Report
A 40-year-old female patient presented to us with a history of waxing and waning skin lesions over a course of a year. She initially noticed the lesion 14 months ago which was a red-brown papulonodular eruption over the left buttock which became haemorrhagic and necrotic over the duration of a week. Following this, she consulted a physician who started her on antifungal treatment. The lesion gradually resolved to leave behind a residual hyperpigmented patch with central scarring. The lesion further flared up after a gap of two months. Allergic etiology was initially considered, and corticosteroids and antiallergics were prescribed. There were two more similar episodes of events over the duration of the next eight months for which she received courses of antibiotics, emollients and antifungals. A diffuse hyperpigmented patch of 5 × 4 cm in dimension with a single well-defined hyperpigmented macule centrally associated with scarring on the surface of the left buttock. Perilesional scaling was also present (Fig 1).There was no mention of pruritis. Mucous membranes, palms and soles were not affected. No enlarged lymph nodes in a local or distant region. The history revealed no consistent systemic B symptoms. Among the differential diagnosis were lymphomatoid papulosis, other cutaneous lymphomas, histiocytosis, sarcoidosis and cutaneous T cell neoplasm.
A skin biopsy revealed an interstitial infiltration of atypical cells without epidermotropism in the dermis and subcutaneous tissues. The tumour cells had ill-defined borders, moderate to abundant cytoplasm and oval, elongated or cleaved nuclei with occasional nucleoli with pale to hyperchromatic chromatin. The background consisted of some T cells and scattered small lymphocytes. (Fig 2) Immunohistochemistry, the atypical cells showed positive staining for leukocyte common antigen (LCA), CD30, CD68, and CD4 (Fig 3,4) while negative for CD20, CD45, MPO, CD34, CD117, ALK, PAX-5, AND CK; Ki-67 – 70-80%. (Fig 5) The final diagnoses considered were Lymphamatoid Papulosis Type C or small cell variant of ALCL.[5]A final diagnosis of LyP type C was made based on the waxing and waning course of the disease. Further evaluations including a complete hemogram, chest radiograph, and ultra-sound of the abdomen which did not reveal any abnormality. After careful counselling, patient was asked to be in close observation and steroid cream for local application. Patient was instructed to report she developed any of the following:
- Skin nodules or lesions that has not regressed over a three-month period.
- Enlarged lymph nodes in the neck, axillae, or groin.
- Fever
It is possible that the above signs and symptoms indicate the onset of an infection or an associated malignancy.
After a follow-up of six months, the disease remains in control with no obvious clinical progression
Figure 1, 2, 3, 4
Discussion
Clinically, lymphomatoid papulosis is characterized by waxing and waning popular or papulo-necrotic eruptions. There may be lesions at different stages of evolution and regression. Individual lesions usually last for 4-6 weeks, but the eruption persists indefinitely and may have a long duration. [6][6,7]The histological findings are variable and one lesion may show overlapping features.[8]In lymphomatoid papulosis, there are five classically recognized histopathologic subtypes: A, B, C, D, and E, based on the predominant cell type and tropism. [7] Type A accounts for 75% of all cases and has been associated with early relapse. Multiple subtypes are often seen in one histopathology section or in different biopsies taken from the same patient, suggesting that these entities overlap. The histological findings are variable and one lesion may show overlapping features.[8]Except for a few exceptions, there is no solid clinical pathological correlation between LyP subtypes.[6,7]
The proliferating cells in LyP are typically CD3+, CD4+, CD25+, CD30+, (Ki-1), CD45RO+ and express HLA-DR. The majority of CD30-negative cases are type B LyP (77% of cases), while some are type D LyP. Type D and E LyP mainly expresses CD8+.[9] This marker is also seen in many cases of LyP in children. There is a variable expression of pan-T-cell antigens, althoughCD2, CD3, CD5 and CD7 are commonly absent. Other positive markers that can be seen include cytotoxic molecules such as T-cell intracellular antigen 1 (TIA-1), granzyme B and perforin. LyP biopsies show CD56 positivity in 10%; CD15 positivity in 18%, and epithelial membrane antigen (EMA) negativity in most cases..[10–12]
Due to the benign nature of the disease and the lack of evidence that therapeutic interventions can change the course of the disease or prevent a second neoplasm, active non-intervention or a ‘wait-and-see’ strategy may be the best course of action.[7,13,14] For localized lesions, surgical excision or radiotherapy can be considered while for disseminated disease phototherapy or methotrexate have been considered.[7,14]
Overall, LyP has good prognosis and disease follows a benign course. [7,15] Although it has a 10-year disease-specific survival of almost 100%, approximately 20% of patients are at risk for developing a second lymphoid neoplasm such as mycosis fungoides, primary cutaneous ALCL and Hodgkin lymphoma. These associated malignancies may occur simultaneously, after or before onset of LyP. [13,15,16] To the best of our knowledge, this is the first case report from India of a type C lymphomatoid papulosis. Limitations of this study is short follow up period.
Conclusion
The lymphomatoid papulosis (LyP) is a rare chronic lymphoproliferative disorder characterized by recurrent erythematous papules and nodules. As we demonstrate in our case, it is important to consider rare disease entities when differentially diagnosing patients. In these rare diseases where there is a lack of data, it is also crucial to provide proper patient counseling and education.
Reference
1. Kunishige JH, McDonald H, Alvarez G, Johnson M, Prieto V, Duvic M. Lymphomatoid papulosis and associated lymphomas: a retrospective case series of 84 patients. Clin Exp Dermatol 2009.34(5):576–581.
2. Alaggio R, Amador C, Anagnostopoulos I, Attygalle AD, Araujo IB de O, Berti E, et al. The 5th edition of the World Health Organization Classification of Haematolymphoid Tumours: Lymphoid Neoplasms. Leukemia 2022.36(7):1720–1748.
3. Willemze R, Jaffe ES, Burg G, Cerroni L, Berti E, Swerdlow SH, et al. WHO-EORTC classification for cutaneous lymphomas. Blood 2005.105(10):3768–3785.
4. Mori M, Manuelli C, Pimpinelli N, Mavilia C, Maggi E, Santucci M, et al. CD30-CD30 ligand interaction in primary cutaneous CD30(+) T-cell lymphomas: A clue to the pathophysiology of clinical regression. Blood 1999.94(9):3077–3083.
5. Magro CM, Momtahen S, Kiuru M. Primary Cutaneous Small Cell Variant of Anaplastic Large Cell Lymphoma: A Case Series and Review of the Literature. Am J Dermatopathol 2017.39(12):877–889.
7. Martinez-Cabriales S A., Walsh S, Sade S, Shear N h. Lymphomatoid papulosis: an update and review. J Eur Acad Dermatol Venereol 2020.34(1):59–73.
8. Goodlad JR. The many faces of lymphomatoid papulosis. Diagn Histopathol 2014.20(7):263–270.
9. Pindado-Ortega C, Fonda-Pascual P, Buendía-Castaño D, Fernández-González P, Peña-Jaimes L, Carrillo-Gijón R. An unusual case of lymphomatoid papulosis type E with extensive necrosis. Indian J Dermatol Venereol Leprol 2018.84:515.
10. Kaudewitz P, Burg G, Stein H, Klepzig K, Mason DY, Braun-Falco O. Monoclonal antibody patterns in lymphomatoid papulosis. Dermatol Clin 1985.3(4):749–757.
11. Wood GS, Strickler JG, Deneau DG, Egbert B, Warnke RA. Lymphomatoid papulosis expresses immunophenotypes associated with T cell lymphoma but not inflammation. J Am Acad Dermatol 1986.15(3):444–458.
12. Varga FJ, Vonderheid EC, Olbricht SM, Kadin ME. Immunohistochemical distinction of lymphomatoid papulosis and pityriasis lichenoides et varioliformis acuta. Am J Pathol 1990.136(4):979–987.
13. AbuHilal M, Walsh S, Shear N. Associated Hematolymphoid Malignancies in Patients With Lymphomatoid Papulosis: A Canadian Retrospective Study. J Cutan Med Surg 2017.21(6):507–512.
14. Kempf W, Pfaltz K, Vermeer MH, Cozzio A, Ortiz-Romero PL, Bagot M, et al. EORTC, ISCL, and USCLC consensus recommendations for the treatment of primary cutaneous CD30-positive lymphoproliferative disorders: lymphomatoid papulosis and primary cutaneous anaplastic large-cell lymphoma. Blood 2011.118(15):4024–4035.
15. Bekkenk MW, Geelen FA, van Voorst Vader PC, Heule F, Geerts ML, van Vloten WA, et al. Primary and secondary cutaneous CD30(+) lymphoproliferative disorders: a report from the Dutch Cutaneous Lymphoma Group on the long-term follow-up data of 219 patients and guidelines for diagnosis and treatment. Blood 2000.95(12):3653–3661.
16. Liu HL, Hoppe RT, Kohler S, Harvell JD, Reddy S, Kim YH. Cd30+ cutaneous lymphoproliferative disorders: The stanford experience in lymphomatoid papulosis and primary cutaneous anaplastic large cell lymphoma. J Am Acad Dermatol 2003.49(6):1049–1058.

Figure 1

Figure 2

Figure 3
Figure 4
